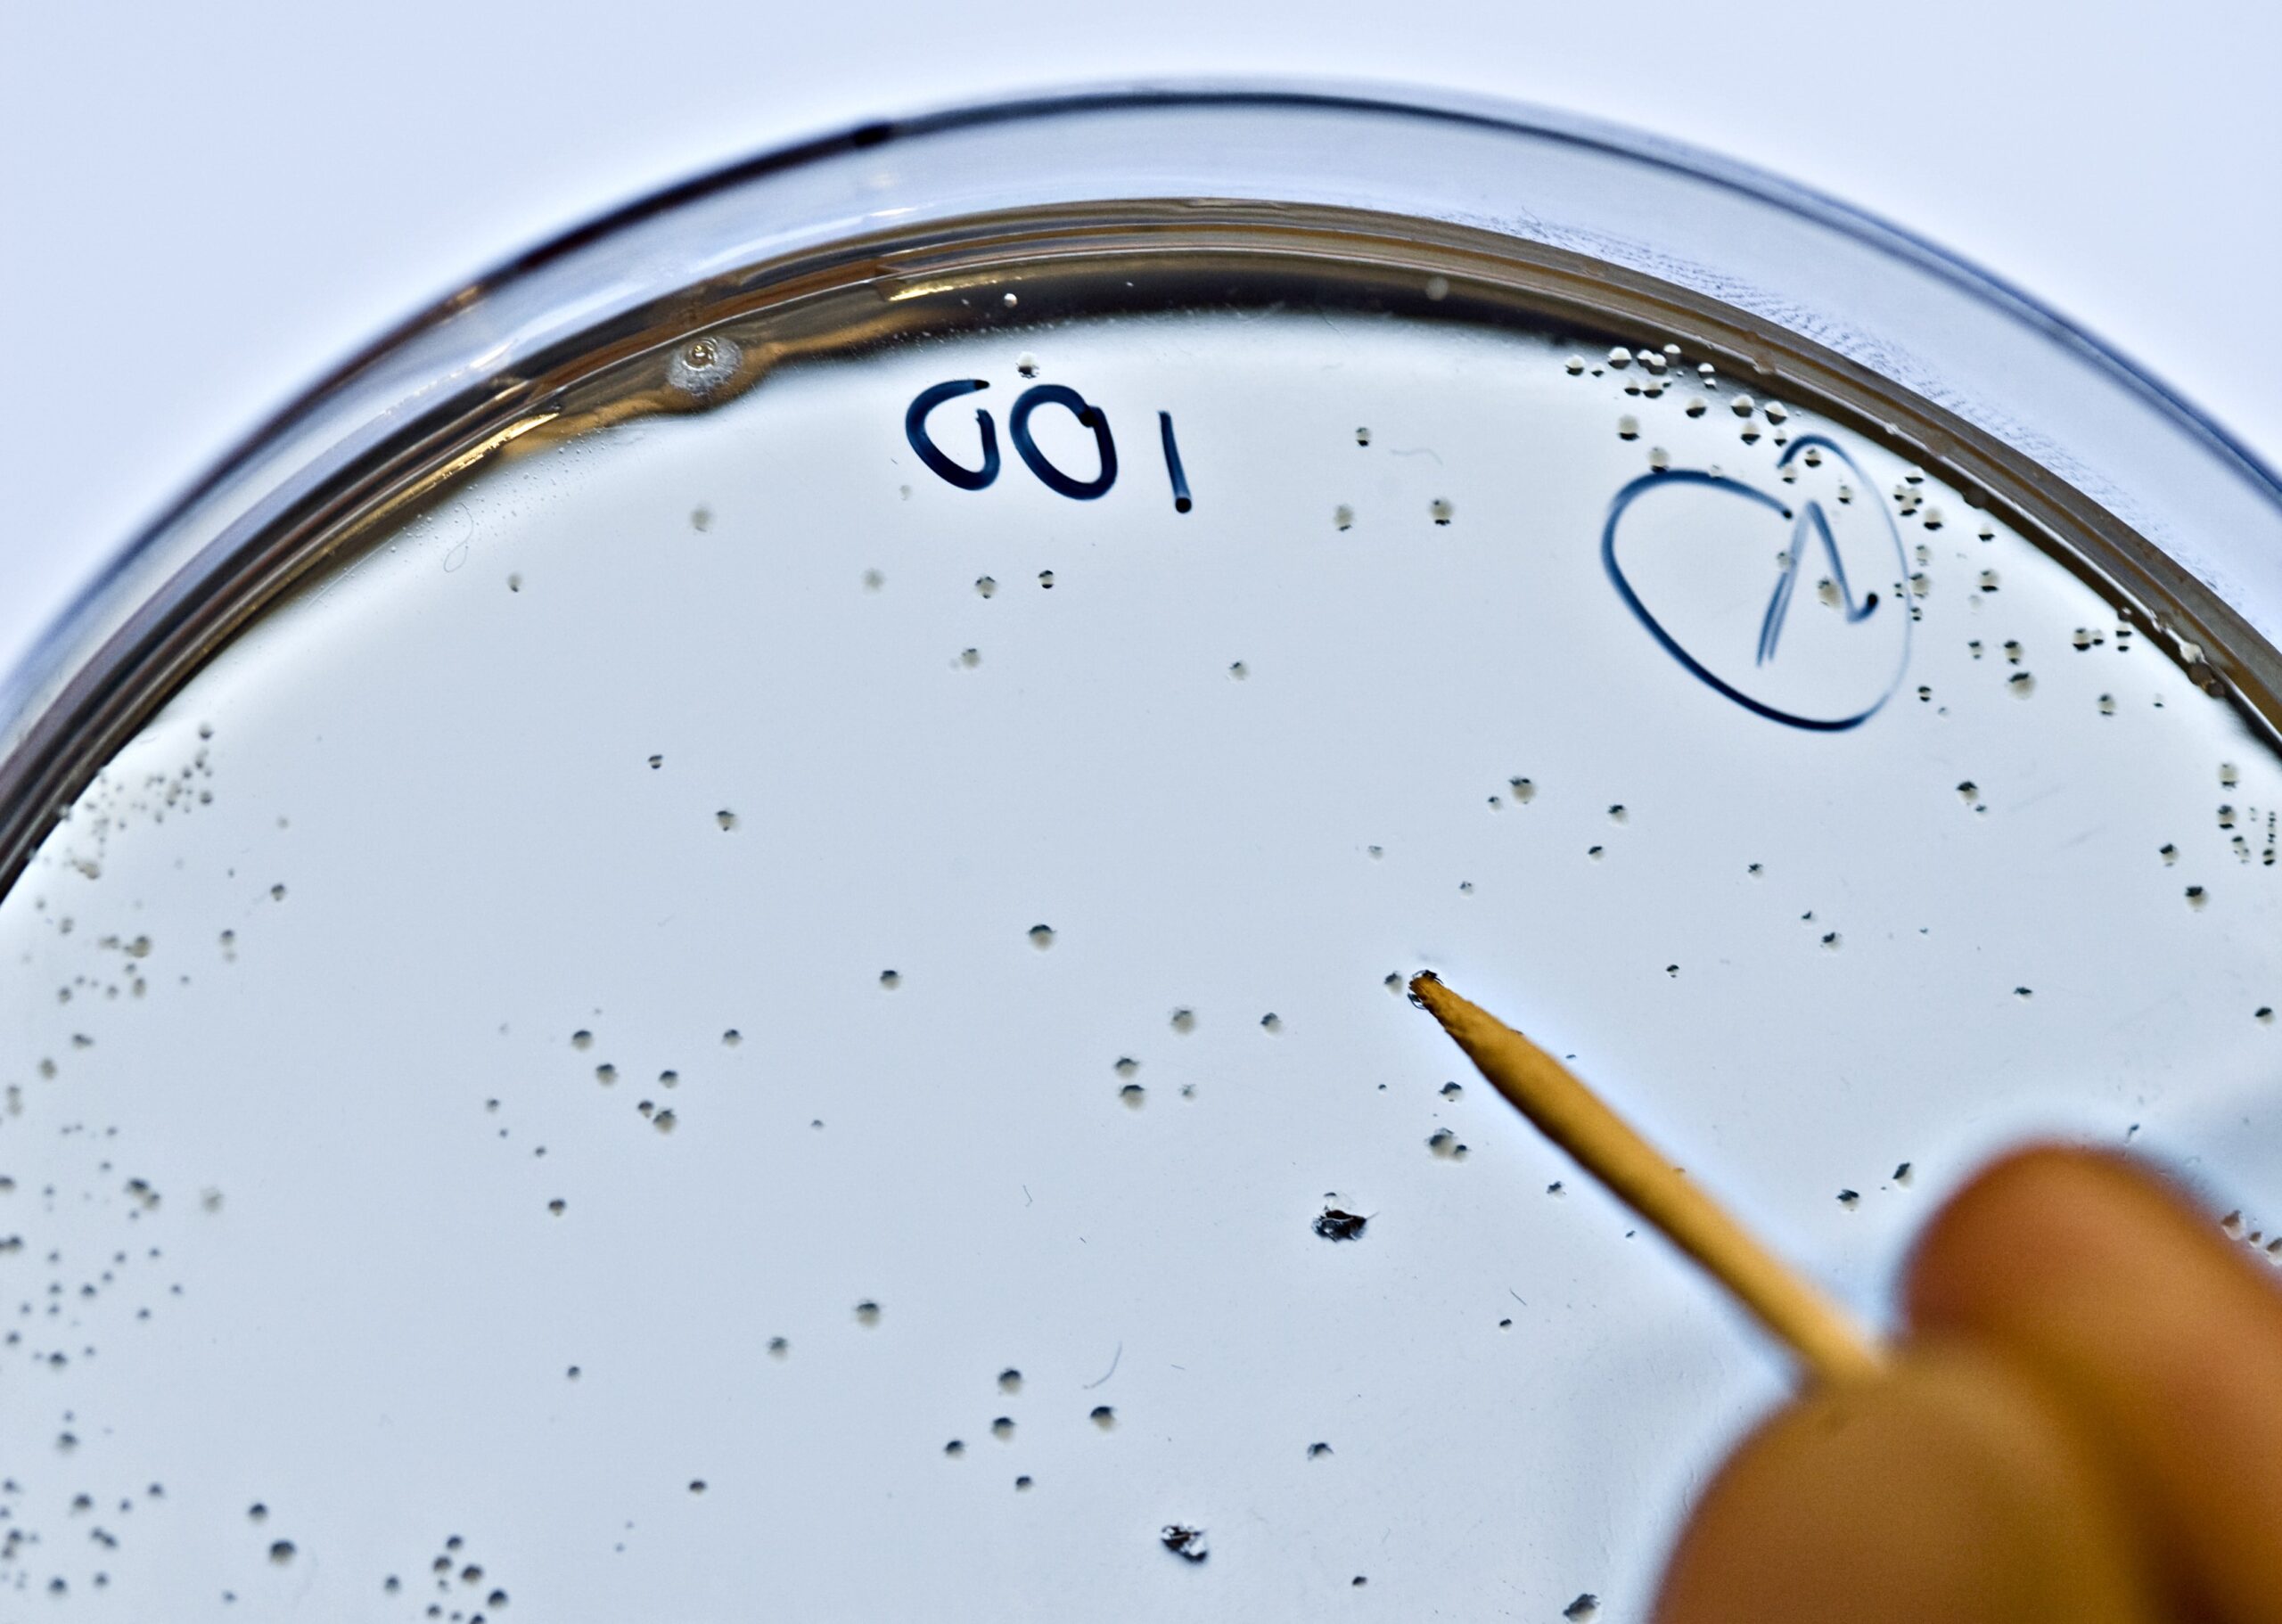

Commissie Genetische Modificatie
De COGEM adviseert de regering over veiligheid van genetische modificatie en signaleert ethisch-maatschappelijke thema's
Nieuws
Blijf op de hoogte van het laatste nieuws, actuele ontwikkelingen en aankomende evenementen van de COGEM.
Publicaties
Publicaties in
voorbereiding
Bekijk aan welke adviezen en (onderzoeks)projecten er momenteel bij de COGEM wordt gewerkt.
Aankomende publicatiesUitgelichte publicaties
Bekijk hier een selectie van publicaties die recent door de COGEM zijn uitgebracht.